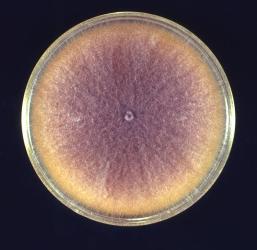
CDC Fusarium

Seven agronomic factors (crop season, farming system, harvest date, moisture, county, oat variety, and previous crop) were recorded for 202 oat crops grown across Ireland, and samples were analysed by LC-MS/MS for four major Fusarium mycotoxins: deoxynivalenol (DON), zearalenone (ZEN), T-2 toxin and HT-2 toxin. Type A trichothecenes were present in 62% of crops, with 7.4% exceeding European regulatory limits. DON (6.4%) and ZEN (9.9%) occurrences were relatively infrequent, though one and three samples were measured over their set limits, respectively. Overall, the type of farming system and the previous crop were the main factors identified as significantly influencing mycotoxin prevalence or concentration. Particularly, the adherence to an organic farming system and growing oats after a previous crop of grass were found to decrease contamination by type A trichothecenes. These are important findings and may provide valuable insights for many other types of cereal crops as Europe moves towards a much greater organic-based food system.
